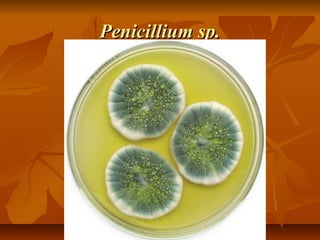
Penicillium sp.

Este documento describe las características y clasificación de los hongos. Los hongos son heterótrofos con pared celular de quitina y pueden ser unicelulares o pluricelulares. Se reproducen de forma asexual a través de gemación, fragmentación o conidios, y de forma sexual a través de la fusión de células. Los hongos se clasifican en zigomicetos, deuteromicetos, ascomicetos, basidiomicetos y líquenes.